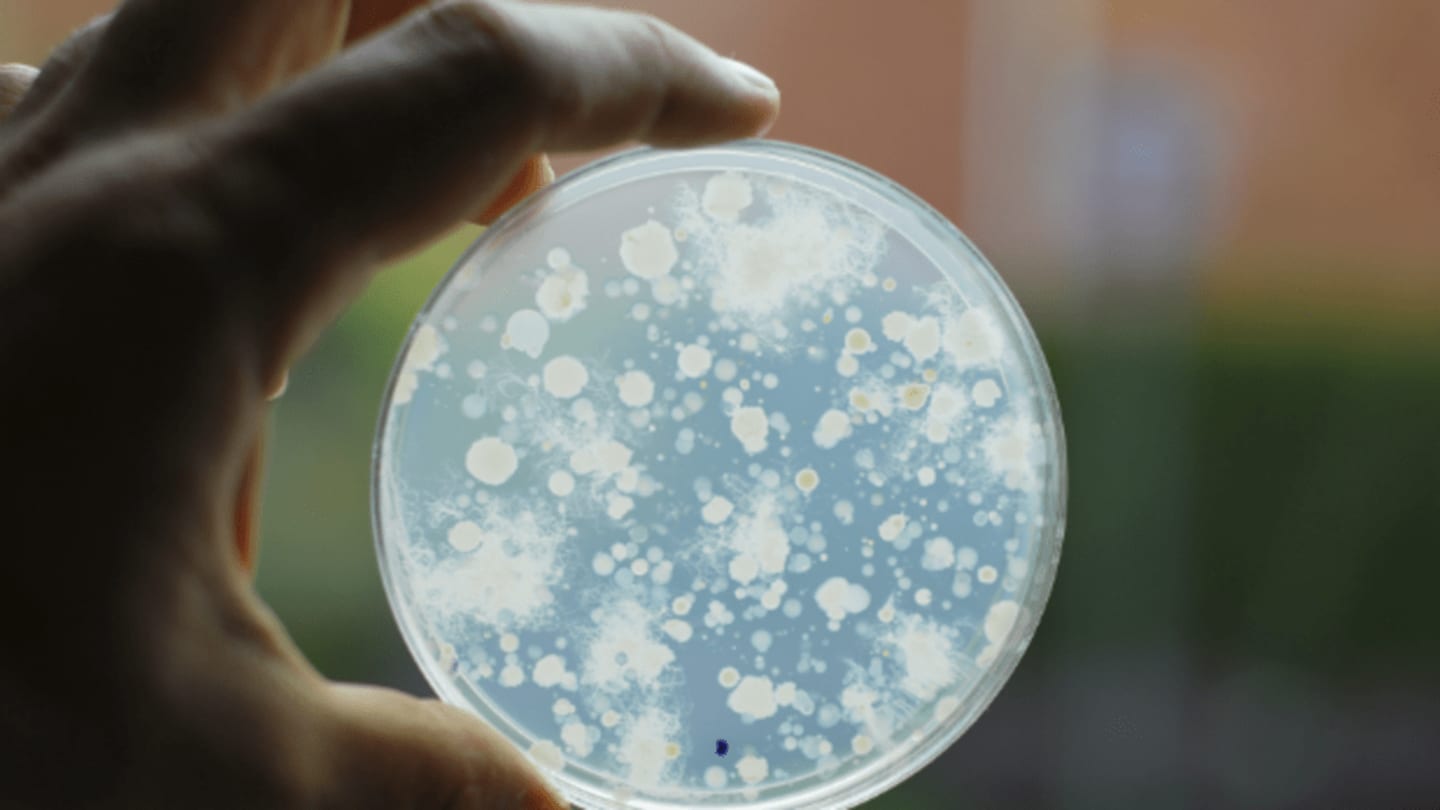

Бактерии воздуха помещений
Бактерии воздуха помещений 112 фото
Аффирмация на каждый день на удачу
Испытания на воздействие радиации
Оформление ухода за матерью
К однодольным водорослям относится
Пхрд в офтальмологии что это
К каким рыбам относится хариус
Шестерня эвотек 2.7
Топогеодезическая привязка
Дзека монолог фармацевта
Самолет без нее читать
Как замариновать овощи для запекания
Птф гранта артикул
Кириллица и глаголица картинки
Опора заднего амортизатора мазда сх 5
Боль при разгибании большого пальца
Грамматический перевод с английского на русский
Картинки раннего детства
Поварского мастерства
Lacoste туалетная вода l homme
Большие алкогольные коктейли